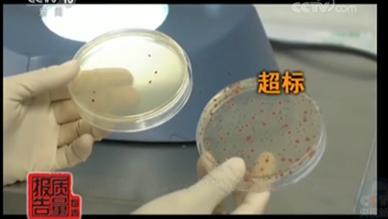
化妆品致面部过敏红肿如何消退,皮肤过敏化妆品是不是不能用了

化妆品逐步成为世界上最大的新兴市场,是颜值社会最好体现。从央视的每周质量报告爆出,某些企业的面膜产品抽检中有着多批次的严重不达标,用了甚至还可能会毁容!

而药监局也在9月12日,对生产这些产品批次的企业发出通告。

面膜属于化妆品的护理品,我们从先化妆品开始说起,全球的美容生态产业分为三类:生活美容、医疗美容,化妆品。生活美容服务范围在护肤、护发,美体等方面,医疗美容则是大到医院的整容,小到私人美容诊所。而化妆品则是分为清洁、护理,美妆三大方面。
菌落种数是一个卫生指标,常常用于医药领域,它能够反应产品的一个卫生情况。一款名为正宗婴儿面膜超标1000倍,甚至还有一种是蓝莓嫩肤细致面膜竟然超标高达7200倍,这两者均被确定均为假冒伪劣产品。这些假冒伪劣的面膜不但没有达到美容的目的,反而消费者还会因此被毁容,面部长粉刺、*血丝红**、痘痘的情况。
面膜质量问题都出在哪个环节或方面,又有什么危害?
在这次曝光中,对生产面膜环节把关不严的企业和违法犯罪的企业都进行了通告。
对于出现菌落过多等产品问题的企业,在无菌生产环节存在严重问题。而一些菌落过多的面膜如果敷在脸上会有两种情况,一种是假如菌落是一种致病菌,恰好你那个时候皮肤有伤口破损,那么致病菌就会通过伤口进入体内,引发疾病。还有多一种情况就是,菌落是细菌的话,有可能会发生像伤口一样继发性的感染,使得伤口大面积溃疡。
违法犯罪的企业非法添加的是糖皮质激素,该激素一般用于病情危重抢救,具有抗炎,抗过敏,抗休克等多种作用。该激素是明令禁止在化妆品使用的。该激素的添加会使脸部皮肤出现两种情况,第一是能够收缩毛细血管,有些红的或者敏感的皮肤一收缩也就变的美白了。第二就是激素可以水纳处理的,含水量增加,短期内你的细胞角质层细胞吸收后,遮光度的发生变化,会显的水嫩有光泽。那这个水纳就是短期破坏脸部的水平衡,使得使用者出现短期的水肿现象。不知情的人,往往的会认为这就是水嫩饱满亮丽。
更为可怕的是,长期使用添加这类激素的面膜,可能会变成干燥脱屑的“激素脸”,大剂量使用糖皮质激素者不宜怀孕。但若哺乳期妇女长期使用这类面膜还可能会未出生的婴儿造成不良影响,怀孕期的妇女使用还有可能造成婴儿畸形。老年患者使用这类假冒伪劣面膜也会有高血压和骨质疏松的患病危险。

那么面膜行业是如何兴起的?
面膜能够为脸部的皮肤带来水嫩的感觉,而中国消费者更是对面膜情有独钟,是世界上人均消费量第一的国家。化妆品在很久以前就存在的,早在70年代,化妆品行业就在萌芽的时期,大多都是国内本土品牌,等到1986年,陆续的有着国外品牌开始进入国内,对国内的本土产品有很大的冲击。等到2002年到2017年我国的销售额复合增速超过20%。

化妆品的高利润众人皆知,化妆品不跟房子一样是刚需。大多数品牌的化妆品比起房价来说,还是挺“亲民”的。为了爱美,仍然有很多女性会选择在自己的经济范围内购买疗效好的化妆品,甚至有些男士也会适量采购一些面膜来护理皮肤。据相关数据统计,人们甚至愿意至少拿出自己的可支配收入的20%来购买化妆品,来装饰精致的自己。
当然也有一些不亲民的进口的高档化妆品产品,例如雅斯兰带曾经著名的Cp+眼霜在国内零售价格达到九百多元,而仅仅只有50ml,平均下来每毫升约18至20元。要知道其制作成本加上研发的费用成本也就仅二三十元的样子。而那些动辄就是几百上千上万的香水,成本几乎就是那些华丽的香水瓶子的价格。

面膜为何假冒伪劣层出不穷?
行业的生产门槛低,原料来源简单,工艺简单,回报利率高,使得很多民间的资本纷纷投入,厂房拔地而起。国内的化妆品厂家仅仅一个市就超过300多家,而美容诊所更是多如牛毛,遍布大街小巷。而市场上的蛋糕就那么多,有了那么多人来分,甚至还有一些外来化妆品企业过来抢分地盘,这也就造成了该行业的竞争激烈和残酷。
不同的企业瞄准的不同消费区间的购买者,有的企业只专做高端,有的企业只做廉价的化妆品,甚至是代工厂。而国内中小微企业占据了大多数,于是在低端的面膜化妆品市场更为激烈,有的企业通过让面膜的疗效更加显著,客户体验感更加强烈,为了更大的利润,更大的销售量,从而使用违禁的添加剂或者药物来达到目的,以刺激销量!

更有甚者,有的企业一直在顾客的皮肤承受点中来回试探,以期望寻找一个平衡点。打着纯草本,纯植物的旗号,大肆敛财。皮肤差的人,使用之后出现红疹痘痘之类的,商家就会说是皮肤过敏,你的皮肤对花粉草本类植物的过敏,建议更换面膜,将责任甩的一干二净。而“你的皮肤对这类化妆产品过敏”,也只是不良企业推脱责任的说辞。
一旦出现这种情况的时候,你想要去维权。可当你输入企业的姓名的时候,在企业公开系统都没有这个企业存在,整个企业就如同幽灵一般,如同当时的“幽灵旅馆”一般,只有在网上开了一间可以订购住宿的店铺,等到你网上付了款自己去到了目的地址的时候,你会发现那里什么都没有,打电话询问却是空号,傻等商家电话打进来安排入住。
或者你幸运搜索到了这个企业,你根据企业信息公示系统查找生产厂家和联系电话的时候,打过去之后你会发现是空号,要么就说你打错了号码!
据有关机关解释,存在这种情况有两种解释,一种是该企业被查封后,后续还有几批商品正在流通,在产品有效期内。又或者是被其他不法的企业钻漏洞,打擦边球生产假冒伪劣产品。毕竟虽然这个企业过期了,生产证号失效了,但是这个证号仍然存在可以被查询。
而皮肤承受力好的人,初期使用会因为面膜的水纳处理,皮肤含水量增加,觉得摸起来看起来皮肤白水嫩多了,但是,值得注意的是当你坚持使用一段时间后,你的细胞可能会活性会下降,皮肤代谢会下降,久了以后皮肤会变得容易变干,久了还会毛细血管扩张。
我们在日常生活中,应该注意一些什么?
首先第一步,应该牢记以下违规的企业和产品,避免自己置身于假冒伪劣产品的浪潮之下。

如果经济允许的情况下,建议消费者们直接去品牌直营店(官方旗舰店),这类商铺比起专卖店、专营店要靠谱的许多。一个品牌有且只有一家店!而直营店往往都有以下等标记。



如果偏爱代购之类的消费者,切忌要选择信的过的人。建议你先先去官网看价格,然后根据汇率算出rmb的价格。代购费一般在10元左右,加上就是产品的价格了。专柜偶尔有活动,大牌顶多打9折。如果你嫌麻烦,只要记住一句话:比免税店还便宜的就不要买!